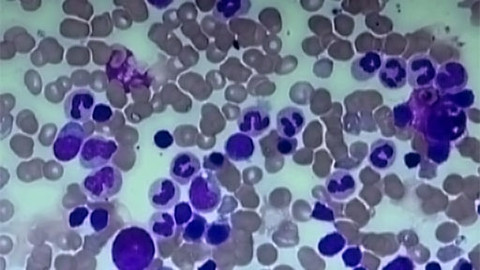
Tep 24 - 10. září 2011

ČT nemá práva k poskytování obsahu online
Tep 24
2. července 2011
Obsah dílu
Nová léčba roztroušené sklerózy? — Léčivé účinky brusinek — Infektolog Luděk Rožnovský
Části dílu
00:55

Nová léčba roztroušené sklerózy?
Nová léčba roztroušené sklerózy? - takzvaná nemoc mladých lidí postihuje mozek a míchu. Dá se léčit, ale nikoliv vyléčit a část pacientů končí na vozíku nebo oslepne. A jak se ukázalo, nemocných přibývá stále rychleji.Lékaři v Ostravě začali stejně jako špičková světová pracoviště ověřovat teorii, že roztroušená skleróza souvisí se špatným tokem krve v cévách a ovlivnit ji může jednoduchý zákrok. Unikátní studii sleduje Česká televize půl roku - společně s příběhy nemocných žen i mužů. Pro ně často znamená naději, lékaři jsou ale zatím opatrní.
10:31

Léčivé účinky brusinek
Prokázané účinky brusinek - u nepříjemných potíží, které můžou třeba zkazit dovolenou nebo mít vážné následky. Infekce močových cest aspoň jednou potrápí každou druhou ženu a mnohé opakovaně. Že na to pomáhají brusinky, není novinka. Vědci a lékaři v Olomouci teď ale v oficiální studii prokázali, jak umí plod známý jako kanadská brusinka ochránit před záněty. Výsledky zajímavého výzkumu uvidíte poprvé právě v Tepu 24.
16:08

Infektolog Luděk Rožnovský
Infektolog Luděk Rožnovský - s bakteriemi všeho druhu a taky s viry, které napadají dospělé i děti, bojuje už čtvrt století. Původně ho lákala jaderná fyzika, zvítězila ale medicína. Namísto atomů zkoumá netypické vyrážky, průjmy, žloutenky, hrozivé meningitidy, klíšťové encefalitidy, malárie nebo AIDS - ale taky stavy, kde přesnou diagnózu určit prostě nelze. Do tajů oboru, kterému se stručně říká infekce, vás zasvětí šéf infekční kliniky FN v Ostravě.
24:19

Stručný přehled
ČT nemá práva pro internet
Stopáž26 minut
10. září 2011
Přehled dílů
63 přehratelných

Stopáž27 minut
21. prosince 2013
Příběhy plné naděje
Poslední vysílání 21. 12. 2013 na ČT24

Stopáž27 minut
7. prosince 2013
Pomoc ostatním ze strany samotných pacientů
Poslední vysílání 7. 12. 2013 na ČT24

Stopáž27 minut
23. listopadu 2013
Vrozené vývojové vady — Rozštěp močového měchýře — Deformity kyčelních nebo kolenních kloubů — Diagnostika vad
Poslední vysílání 23. 11. 2013 na ČT24

Stopáž27 minut
9. listopadu 2013
Darování krve — Složky krve — Transplantace kostní dřeně
Poslední vysílání 9. 11. 2013 na ČT24

Stopáž27 minut
26. října 2013
Srdeční onemocnění — Svorka na srdeční chlopně — Děti se srdeční vadou
Poslední vysílání 26. 10. 2013 na ČT24

Stopáž26 minut
12. října 2013
Revmatické choroby
Poslední vysílání 12. 10. 2013 na ČT24

Stopáž26 minut
28. září 2013
Zubní implantáty — Prevence u dětí
Poslední vysílání 28. 9. 2013 na ČT24

Stopáž26 minut
14. září 2013
Rok v bezvědomí — Bezvědomí a paměť — Bazální stimulace
Poslední vysílání 14. 9. 2013 na ČT24

Stopáž27 minut
22. června 2013
Historie i přítomnost radiologie — Intervenční radiologie a hluboká žilní trombóza — Antikoncepce
Poslední vysílání 22. 6. 2013 na ČT24

Stopáž26 minut
8. června 2013
Dětská onkologie — Příběh Barbory — Rakovina kůže
Poslední vysílání 8. 6. 2013 na ČT24



